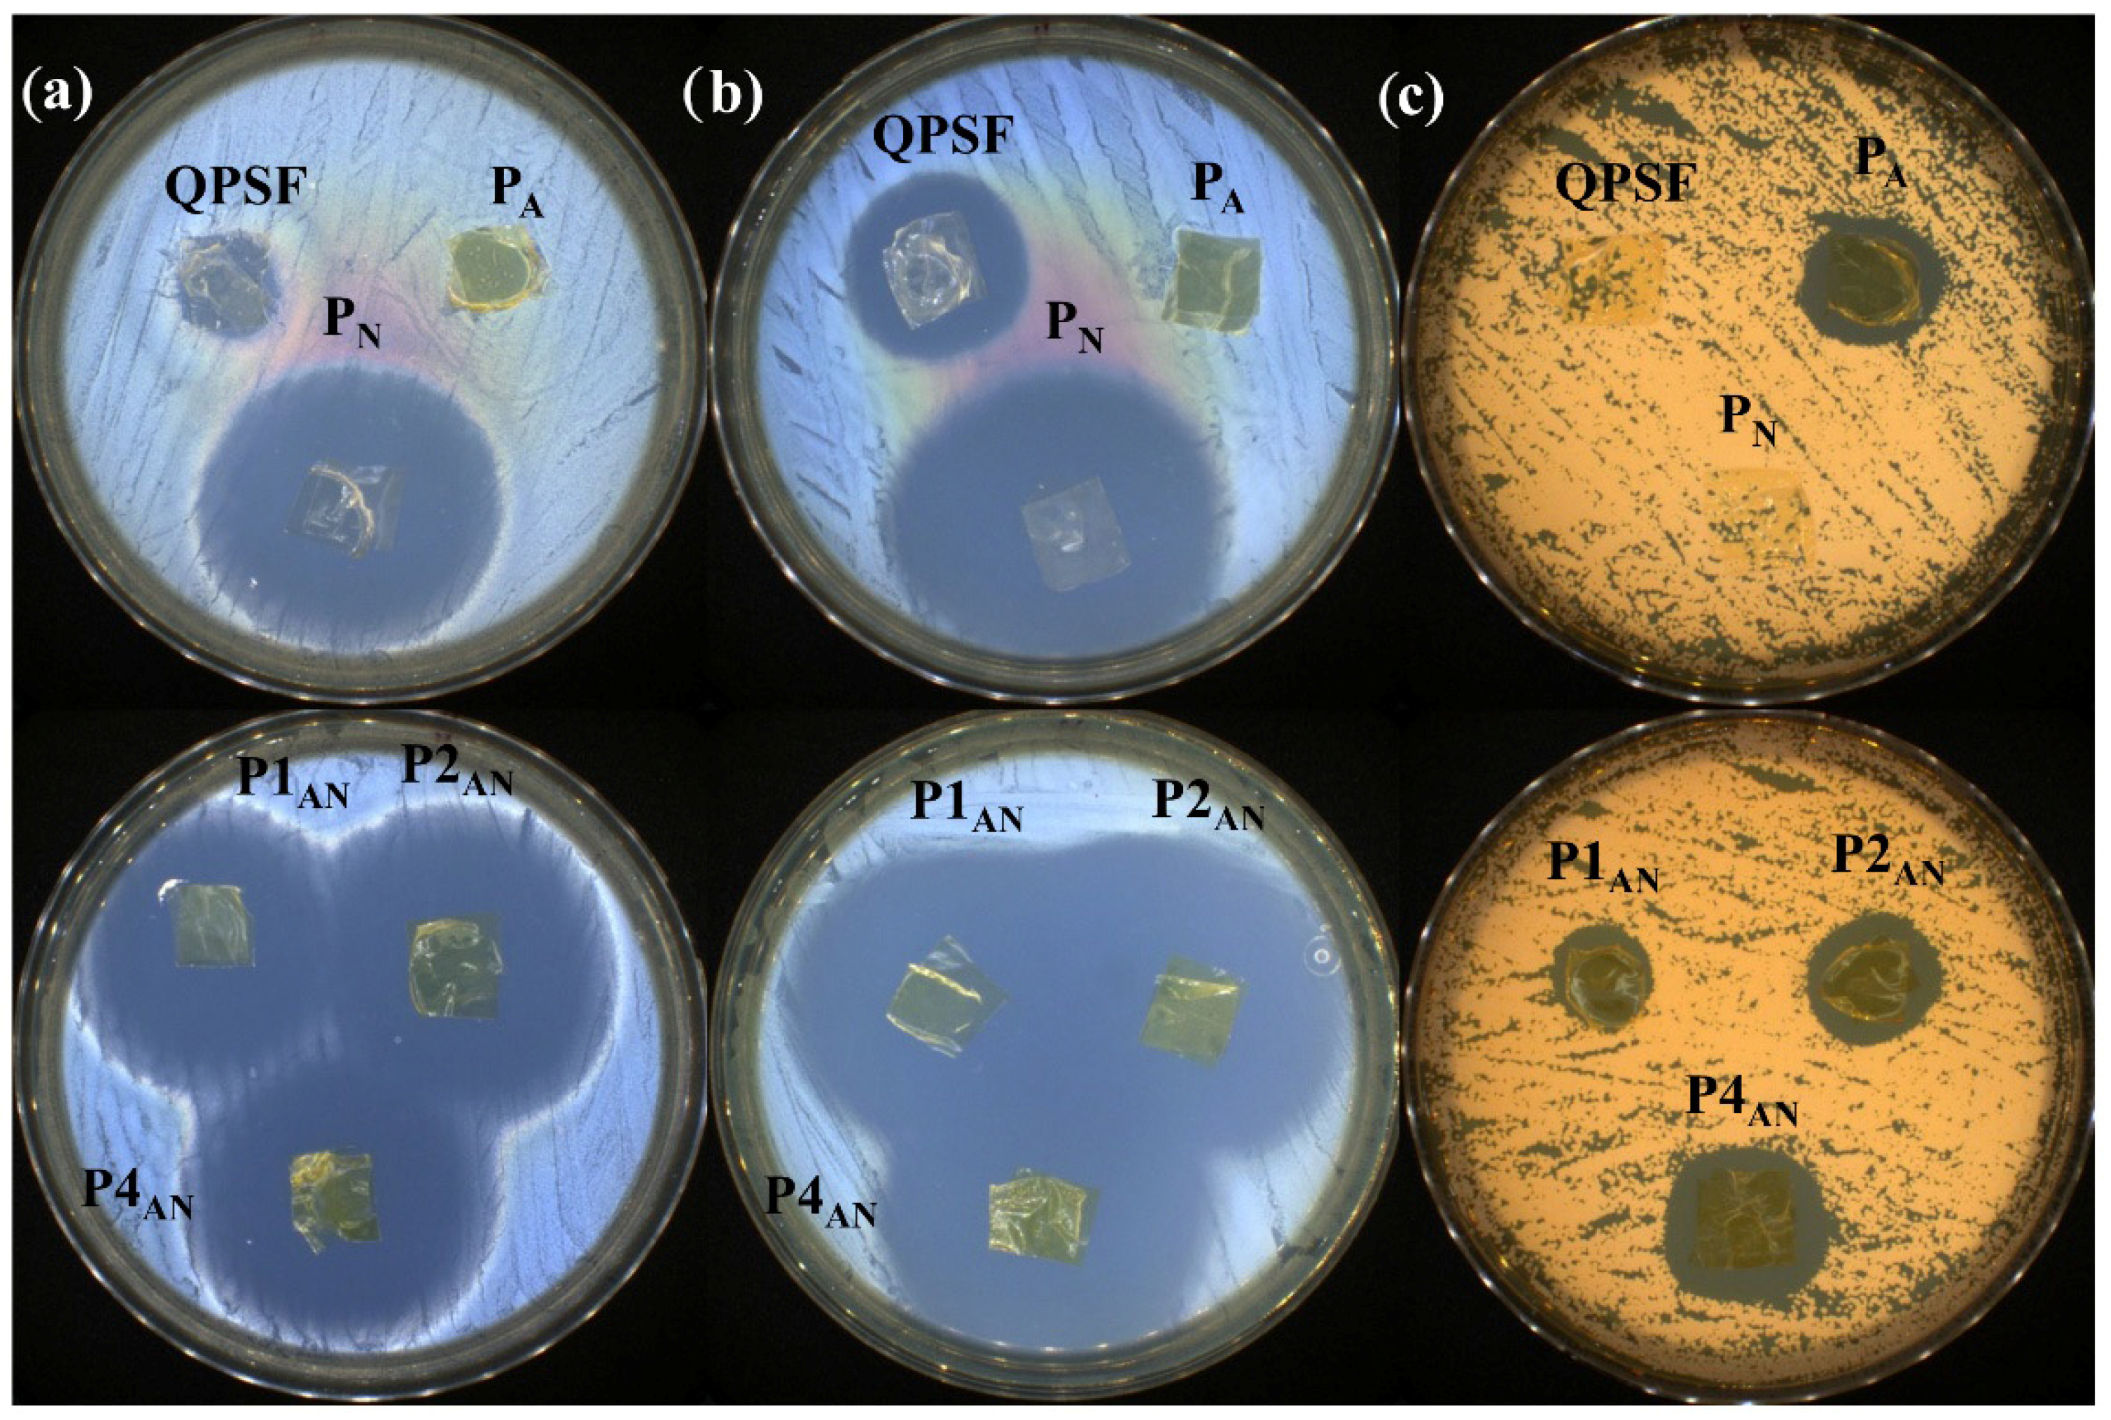
Polymers 17 01869 g012

Quaternized Polysulfones as Matrix for the Development of Broad-Spectrum Antimicrobial Coatings for Medical Devices
Abstract
1. Introduction
2. Materials and Methods
2.1. Materials
2.2. Synthesis of QPSF
2.3. Preparation of Formulations
2.4. Characterization
- (i)
- Zero order model: , where is the amount of drug dissolved in the time and is the Zero order release constant.
- (ii)
- First order model: , where is the amount of drug released in the time , is the initial amount of drug and is the first order release constant.
- (iii)
- Higuchi model: , where is the amount of drug released in the time and is the Higuchi dissolution constant.
- (iv)
- Hixson–Crowell model: , where is the initial amount of drug in the coating, is the remaining amount of drug in the formulation at time and is a constant.
- (v)
- Korsmeyer–Peppas model: , where is the fraction of drug released at the time , is the release rate constant and is the release exponent.
3. Results
3.1. Structural Characterization
3.2. Morphological Characterization
3.3. Surface Properties
3.4. Release Kinetics and Fitting on Mathematical Models
3.5. Antioxidant Activity Using the DPPH Method
3.6. Antimicrobial Activity
4. Conclusions
Supplementary Materials
Author Contributions
Funding
Institutional Review Board Statement
Data Availability Statement
Conflicts of Interest
References
- Jain, S.; Nehra, M.; Kumar, R.; Dilbaghi, N.; Hu, T.Y.; Kumar, S.; Kaushik, A.; Li, C.-Z. Internet of Medical Things (IoMT)-Integrated Biosensors for Point-of-Care Testing of Infectious Diseases. Biosens. Bioelectron. 2021, 179, 113074. [Google Scholar] [CrossRef] [PubMed]
- Jiang, X.; Yao, Y.; Tang, W.; Han, D.; Zhang, L.; Zhao, K.; Wang, S.; Meng, Y. Design of Dental Implants at Materials Level: An Overview. J. Biomed. Mater. Res. A 2020, 108, 1634–1661. [Google Scholar] [CrossRef] [PubMed]
- Qu, Y.; McGiffin, D.; Hayward, C.; McLean, J.; Duncan, C.; Robson, D.; Kure, C.; Shen, R.; Williams, H.; Mayo, S.; et al. Characterization of Infected, Explanted Ventricular Assist Device Drivelines: The Role of Biofilms and Microgaps in the Driveline Tunnel. J. Heart Lung Transplant. 2020, 39, 1289–1299. [Google Scholar] [CrossRef] [PubMed]
- Salwiczek, M.; Qu, Y.; Gardiner, J.; Strugnell, R.A.; Lithgow, T.; McLean, K.M.; Thissen, H. Emerging Rules for Effective Antimicrobial Coatings. Trends Biotechnol. 2014, 32, 82–90. [Google Scholar] [CrossRef]
- Devine, R.; Douglass, M.; Ashcraft, M.; Tayag, N.; Handa, H. Development of Novel Amphotericin B-Immobilized Nitric Oxide-Releasing Platform for the Prevention of Broad-Spectrum Infections and Thrombosis. ACS Appl. Mater. Interfaces 2021, 13, 19613–19624. [Google Scholar] [CrossRef]
- de Lissovoy, G.; Fraeman, K.; Hutchins, V.; Murphy, D.; Song, D.; Vaughn, B.B. Surgical Site Infection: Incidence and Impact on Hospital Utilization and Treatment Costs. Am. J. Infect. Control 2009, 37, 387–397. [Google Scholar] [CrossRef]
- Harder, E.E.; Gaies, M.G.; Yu, S.; Donohue, J.E.; Hanauer, D.A.; Goldberg, C.S.; Hirsch, J.C. Risk Factors for Surgical Site Infection in Pediatric Cardiac Surgery Patients Undergoing Delayed Sternal Closure. J. Thorac. Cardiovasc. Surg. 2013, 146, 326–333. [Google Scholar] [CrossRef]
- Saito, Y.; Kobayashi, H.; Uetera, Y.; Yasuhara, H.; Kajiura, T.; Okubo, T. Microbial Contamination of Surgical Instruments Used for Laparotomy. Am. J. Infect. Control 2014, 42, 43–47. [Google Scholar] [CrossRef]
- Cooper, I.R.; Pollini, M.; Paladini, F. The Potential of Photo-Deposited Silver Coatings on Foley Catheters to Prevent Urinary Tract Infections. Mater. Sci. Eng. C 2016, 69, 414–420. [Google Scholar] [CrossRef]
- Lim, K.; Chua, R.R.Y.; Ho, B.; Tambyah, P.A.; Hadinoto, K.; Leong, S.S.J. Development of a Catheter Functionalized by a Polydopamine Peptide Coating with Antimicrobial and Antibiofilm Properties. Acta Biomater. 2015, 15, 127–138. [Google Scholar] [CrossRef]
- Singha, P.; Locklin, J.; Handa, H. A Review of the Recent Advances in Antimicrobial Coatings for Urinary Catheters. Acta Biomater. 2017, 50, 20–40. [Google Scholar] [CrossRef] [PubMed]
- Czerwińska-Główka, D.; Przystaś, W.; Zabłocka-Godlewska, E.; Student, S.; Cwalina, B.; Łapkowski, M.; Krukiewicz, K. Electrically-Responsive Antimicrobial Coatings Based on a Tetracycline-Loaded Poly(3,4-Ethylenedioxythiophene) Matrix. Mater. Sci. Eng. C 2021, 123, 112017. [Google Scholar] [CrossRef] [PubMed]
- Pinho, A.C.; Piedade, A.P. Polymeric Coatings with Antimicrobial Activity: A Short Review. Polymers 2020, 12, 2469. [Google Scholar] [CrossRef]
- Filimon, A.; Olaru, N.; Doroftei, F.; Coroaba, A.; Dunca, S. Processing of Quaternized Polysulfones Solutions as Tool in Design of Electrospun Nanofibers: Microstructural Characteristics and Antimicrobial Activity. J. Mol. Liq. 2021, 330, 115664. [Google Scholar] [CrossRef]
- Bargan, A.; Onofrei, M.D.; Stoica, I.; Doroftei, F.; Dunca, S.; Filimon, A. Materials Based on Quaternized Polysulfones with Potential Applications in Biomedical Field: Structure–Properties Relationship. Int. J. Mol. Sci. 2022, 23, 4721. [Google Scholar] [CrossRef]
- Dumbrava, O.; Filimon, A.; Marin, L. Tailoring Properties and Applications of Polysulfone Membranes by Chemical Modification: Structure-Properties-Applications Relationship. Eur. Polym. J. 2023, 196, 112316. [Google Scholar] [CrossRef]
- Chen, Y.; Lin, B.; Qiu, Y. Modification of Polysulfone and the Biomedical Application of Modified Polysulfone. Int. J. Polym. Mater. Polym. Biomater. 2023, 72, 224–242. [Google Scholar] [CrossRef]
- Wasyłeczko, M.; Wojciechowski, C.; Chwojnowski, A. Polyethersulfone Polymer for Biomedical Applications and Biotechnology. Int. J. Mol. Sci. 2024, 25, 4233. [Google Scholar] [CrossRef]
- Sivaraman, K.M.; Kellenberger, C.; Pané, S.; Ergeneman, O.; Lühmann, T.; Luechinger, N.A.; Hall, H.; Stark, W.J.; Nelson, B.J. Porous Polysulfone Coatings for Enhanced Drug Delivery. Biomed. Microdevices 2012, 14, 603–612. [Google Scholar] [CrossRef]
- Giles, C.; Lamont-Friedrich, S.J.; Michl, T.D.; Griesser, H.J.; Coad, B.R. The Importance of Fungal Pathogens and Antifungal Coatings in Medical Device Infections. Biotechnol. Adv. 2018, 36, 264–280. [Google Scholar] [CrossRef]
- Cyphert, E.L.; von Recum, H.A. Emerging Technologies for Long-Term Antimicrobial Device Coatings: Advantages and Limitations. Exp. Biol. Med. 2017, 242, 788–798. [Google Scholar] [CrossRef] [PubMed]
- Salmanton-García, J.; Cornely, O.A.; Stemler, J.; Barać, A.; Steinmann, J.; Siváková, A.; Akalin, E.H.; Arikan-Akdagli, S.; Loughlin, L.; Toscano, C.; et al. Attributable Mortality of Candidemia—Results from the ECMM Candida III Multinational European Observational Cohort Study. J. Infect. 2024, 89, 106229. [Google Scholar] [CrossRef] [PubMed]
- Wisplinghoff, H.; Seifert, H.; Wenzel, R.P.; Edmond, M.B. Inflammatory Response and Clinical Course of Adult Patients with Nosocomial Bloodstream Infections Caused by Candida spp. Clin. Microbiol. Infect. 2006, 12, 170–177. [Google Scholar] [CrossRef]
- Marsh, P.K.; Tally, F.P.; Kellum, J.; Callow, A.; Gorbach, S.L. Candida Infections in Surgical Patients. Ann. Surg. 1983, 198, 42–47. [Google Scholar] [CrossRef]
- Laniado-Laborín, R.; Cabrales-Vargas, M.N. Amphotericin B: Side Effects and Toxicity. Rev. Iberoam. Micol. 2009, 26, 223–227. [Google Scholar] [CrossRef]
- Vitale, R.G.; Afeltra, J.; de Hoog, G.S.; Rijs, A.J.; Verweij, P.E. In Vitro Activity of Amphotericin B and Itraconazole in Combination with Flucytosine, Sulfadiazine and Quinolones against Exophiala Spinifera. J. Antimicrob. Chemother. 2003, 51, 1297–1300. [Google Scholar] [CrossRef]
- Ghimici, L.; Avram, E. Viscometric Behavior of Quaternized Polysulfones. J. Appl. Polym. Sci. 2003, 90, 465–469. [Google Scholar] [CrossRef]
- Ren, Y.; Huang, L.; Wang, Y.; Mei, L.; Fan, R.; He, M.; Wang, C.; Tong, A.; Chen, H.; Guo, G. Stereocomplexed Electrospun Nanofibers Containing Poly (Lactic Acid) Modified Quaternized Chitosan for Wound Healing. Carbohydr. Polym. 2020, 247, 116754. [Google Scholar] [CrossRef]
- Ailincai, D.; Cibotaru, S.; Anisiei, A.; Coman, C.G.; Pasca, A.S.; Rosca, I.; Sandu, A.I.; Mititelu-Tartau, L.; Marin, L. Mesoporous Chitosan Nanofibers Loaded with Norfloxacin and Coated with Phenylboronic Acid Perform as Bioabsorbable Active Dressings to Accelerate the Healing of Burn Wounds. Carbohydr. Polym. 2023, 318, 121135. [Google Scholar] [CrossRef]
- JIS Z 2801; Antibacterial Products—Test for Antibacterial Activity and Efficacy. Japan Standards Association (JSA): Tokyo, Japan, 2010; p. jis.z.2801.e.2010.
- Bauer, A.W.; Perry, D.M.; Kirby, W.M.M. Single-Disk Antibiotic-Sensitivity Testing of Staphylococci; an Analysis of Technique and Results. AMA Arch. Intern. Med. 1959, 104, 208–216. [Google Scholar] [CrossRef]
- Sandström, K.; Wärmländer, S.; Leijon, M.; Gräslund, A. 1H NMR Studies of Selective Interactions of Norfloxacin with Double-Stranded DNA. Biochem. Biophys. Res. Commun. 2003, 304, 55–59. [Google Scholar] [CrossRef] [PubMed]
- Rajini Balakrishnan, A.; Easwaran, K.R.K. CD and NMR Studies on the Aggregation of Amphotericin-B in Solution. Biochim. Biophys. Acta (BBA)—Biomembr. 1993, 1148, 269–277. [Google Scholar] [CrossRef]
- Alkhouzaam, A.; Qiblawey, H. Novel Polysulfone Ultrafiltration Membranes Incorporating Polydopamine Functionalized Graphene Oxide with Enhanced Flux and Fouling Resistance. J. Membr. Sci. 2021, 620, 118900. [Google Scholar] [CrossRef]
- Sahoo, S.; Chakraborti, C.K.; Behera, P.K.; Mishra, S.C. FTIR and Raman Spectroscopic Investigations of a Norfloxacin/Carbopol934 Polymeric Suspension. J. Young Pharm. 2012, 4, 138–145. [Google Scholar] [CrossRef]
- Gagoś, M.; Arczewska, M. Influence of K+ and Na+ Ions on the Aggregation Processes of Antibiotic Amphotericin B: Electronic Absorption and FTIR Spectroscopic Studies. J. Phys. Chem. B 2011, 115, 3185–3192. [Google Scholar] [CrossRef]
- Vandermeulen, G.; Rouxhet, L.; Arien, A.; Brewster, M.E.; Préat, V. Encapsulation of Amphotericin B in Poly(Ethylene Glycol)-Block-Poly(ε-Caprolactone-Co-Trimethylenecarbonate) Polymeric Micelles. Int. J. Pharm. 2006, 309, 234–240. [Google Scholar] [CrossRef]
- Chang, Y.; Wang, Y.H.; Hu, C.Q. Simultaneous Determination of Purity and Potency of Amphotericin B by HPLC. J. Antibiot. 2011, 64, 735–739. [Google Scholar] [CrossRef]
- Das, I.; Halder, M. Counterpointing Scenarios on the Fate of Different Prototropic Forms of Norfloxacin Housed in the Pocket of Lysozyme: The Nonelectrostatic Interactions in the Protein Interior Are in the Controlling Role on the Prototropic Equilibria of the Guest. ACS Omega 2017, 2, 5504–5517. [Google Scholar] [CrossRef]
- Ailincai, D.; Gavril, G.; Marin, L. Polyvinyl Alcohol Boric Acid—A Promising Tool for the Development of Sustained Release Drug Delivery Systems. Mater. Sci. Eng. C 2020, 107, 110316. [Google Scholar] [CrossRef]
- Vinodh, R.; Purushothaman, M.; Sangeetha, D. Novel Quaternized Polysulfone/ZrO2 Composite Membranes for Solid Alkaline Fuel Cell Applications. Int. J. Hydrogen Energy 2011, 36, 7291–7302. [Google Scholar] [CrossRef]
- Soto, R.; Patel, P.; Albadarin, A.B.; Diniz, M.O.; Hudson, S.P. Solubility, Aggregation and Stability of Amphotericin B Drug in Pure Organic Solvents: Thermodynamic Analysis and Solid Form Characterization. J. Mol. Liq. 2022, 366, 120276. [Google Scholar] [CrossRef]
- Bratu, I.; Borodi, G.; Kacsó, I.; Moldovan, Z.; Filip, C.; Dragan, F.; Vasilescu, M.; Simon, S. New Solid Form of Norfloxacin: Structural Studies. J. Spectrosc. 2011, 25, 53–62. [Google Scholar] [CrossRef]
- Lekoane, T.; Msomi, P.F. Quarternized Polysulfone/ZSM-5 Zeolite Composite Anion Exchange Membrane Separators for Aluminum-Air Battery. J. Appl. Polym. Sci. 2023, 140, e54006. [Google Scholar] [CrossRef]
- Marin, L.; Ailincai, D.; Paslaru, E. Monodisperse PDLC Composites Generated by Use of Polyvinyl Alcohol Boric Acid as Matrix. RSC Adv. 2014, 4, 38397–38404. [Google Scholar] [CrossRef]
- Ailincai, D.; Dorobanu, A.M.; Dima, B.; Irimiciuc, T.A.; Lupacu, C.; Agop, M.; Olguta, O. Poly(Vinyl Alcohol Boric Acid)-Diclofenac Sodium Salt Drug Delivery Systems: Experimental and Theoretical Studies. J. Immunol. Res. 2020, 2020, 3124304. [Google Scholar] [CrossRef]
- Menzies, K.L.; Jones, L. The Impact of Contact Angle on the Biocompatibility of Biomaterials. Optom. Vis. Sci. 2010, 87, 387–399. [Google Scholar] [CrossRef]
- Kumar, S.; Bhushan, P.; Bhattacharya, S. Coatings on Surgical Tools and How to Promote Adhesion of Bio-Friendly Coatings on Their Surfaces. In Adhesion in Pharmaceutical, Biomedical and Dental Fields; John Wiley & Sons: Hoboken, NJ, USA, 2017; pp. 207–233. [Google Scholar] [CrossRef]
- Alias, R.; Mahmoodian, R.; Abd Shukor, M.H. Development and Characterization of a Multilayer Silver/Silver-Tantalum Oxide Thin Film Coating on Stainless Steel for Biomedical Applications. Int. J. Adhes. Adhes. 2019, 92, 89–98. [Google Scholar] [CrossRef]
- Ikada, Y. Surface Modification of Polymers for Medical Applications. Biomaterials 1994, 15, 725–736. [Google Scholar] [CrossRef]
- Young, T. III. An Essay on the Cohesion of Fluids. Philos. Trans. R. Soc. Lond. 1805, 95, 65–87. [Google Scholar] [CrossRef]
- Owens, D.K.; Wendt, R.C. Estimation of the Surface Free Energy of Polymers. J. Appl. Polym. Sci. 1969, 13, 1741–1747. [Google Scholar] [CrossRef]
- Fowkes, F.M. Contact Angle, Wettability, and Adhesion. Adv. Chem. 1964, 43, i–iii. [Google Scholar] [CrossRef]
- Pathote, D.; Kumari, P.; Singh, V.; Jaiswal, D.; Gautam, R.K.; Behera, C.K. Biocompatibility Evaluation, Wettability, and Scratch Behavior of Ta-Coated 316L Stainless Steel by DC Magnetron Sputtering for the Orthopedic Applications. Surf. Coat. Technol. 2023, 459, 129392. [Google Scholar] [CrossRef]
- La Zara, D.; Zhang, F.; Sun, F.; Bailey, M.R.; Quayle, M.J.; Petersson, G.; Folestad, S.; van Ommen, J.R. Drug Powders with Tunable Wettability by Atomic and Molecular Layer Deposition: From Highly Hydrophilic to Superhydrophobic. Appl. Mater. Today 2021, 22, 100945. [Google Scholar] [CrossRef]
- Singh, D.; Dilip Saoji, S. The Role of Surface Energy and Wettability in Polymer-Based Drug Delivery Systems: Enhancing Bioadhesion and Drug Release Efficiency. J. Macromol. Sci. Part B Phys. 2024, 1–8. [Google Scholar] [CrossRef]
- Majhy, B.; Priyadarshini, P.; Sen, A.K. Effect of Surface Energy and Roughness on Cell Adhesion and Growth—Facile Surface Modification for Enhanced Cell Culture. RSC Adv. 2021, 11, 15467–15476. [Google Scholar] [CrossRef]
- Paarakh, M.P.; Jose, P.A.; Setty, C.; Peterchristoper, G.V. Release Kinetics—Concepts and Applications. Int. J. Pharm. Res. Technol. (IJPRT) 2018, 8, 12–20. [Google Scholar] [CrossRef]
- Ailincai, D.; Morariu, S.; Rosca, I.; Sandu, A.I.; Marin, L. Drug Delivery Based on a Supramolecular Chemistry Approach by Using Chitosan Hydrogels. Int. J. Biol. Macromol. 2023, 248, 125800. [Google Scholar] [CrossRef]
- Mathematical Models of Drug Release. In Strategies to Modify the Drug Release from Pharmaceutical Systems; Woodhead Publishing: Cambridge, UK, 2015; pp. 63–86. [CrossRef]
- Osaka, K.; Tyurina, Y.Y.; Dubey, R.K.; Tyurin, V.A.; Ritov, V.B.; Quinn, P.J.; Branch, R.A.; Kagan, V.E. Amphotericin B as an Intracellular Antioxidant: Protection against 2,2′-Azobis(2,4-Dimethylvaleronitrile)-Induced Peroxidation of Membrane Phospholipids in Rat Aortic Smooth Muscle Cells. Biochem. Pharmacol. 1997, 54, 937–945. [Google Scholar] [CrossRef]
- Kancheva, V.D.; Dettori, M.A.; Fabbri, D.; Alov, P.; Angelova, S.E.; Slavova-Kazakova, A.K.; Carta, P.; Menshov, V.A.; Yablonskaya, O.I.; Trofimov, A.V.; et al. Natural Chain-Breaking Antioxidants and Their Synthetic Analogs as Modulators of Oxidative Stress. Antioxidants 2021, 10, 624. [Google Scholar] [CrossRef]
- Alam, R.T.M.; Fawzi, E.M.; Alkhalf, M.I.; Alansari, W.S.; Aleya, L.; Abdel-Daim, M.M. Anti-Inflammatory, Immunomodulatory, and Antioxidant Activities of Allicin, Norfloxacin, or Their Combination against Pasteurella Multocida Infection in Male New Zealand Rabbits. Oxid. Med. Cell. Longev. 2018, 2018, 1780956. [Google Scholar] [CrossRef]
- Cui, J.; Sun, Y.; Wang, L.; Ji, Y.; Zhao, H.; Sun, M.; Guo, Z.; Dong, F. Quaternary Ammonium Salts of Chitosan Containing Aromatic Ring: Synthesis, Characterization, Antimicrobial, Antioxidant and Cytotoxicity. Carbohydr. Res. 2025, 552, 109431. [Google Scholar] [CrossRef] [PubMed]
- Yang, J.; Li, Q.; Oluf, J.; Pan, C.; Cleemann, L.N.; Bjerrum, N.J.; He, R. Phosphoric Acid Doped Imidazolium Polysulfone Membranes for High Temperature Proton Exchange Membrane Fuel Cells. J Power Sources 2012, 205, 114–121. [Google Scholar] [CrossRef]
- Yang, J.; Wang, J.; Liu, C.; Gao, L.; Xu, Y.; Che, Q.; He, R. Influences of the Structure of Imidazolium Pendants on the Properties of Polysulfone-Based High Temperature Proton Conducting Membranes. J. Membr. Sci. 2015, 493, 80–87. [Google Scholar] [CrossRef]
- Liu, Y.; Wang, J. Preparation of Anion Exchange Membrane by Efficient Functionalization of Polysulfone for Electrodialysis. J. Membr. Sci. 2020, 596, 117591. [Google Scholar] [CrossRef]
- Avram, E. Polymers with Pendent Functional Groups. VI. A Comparative Study on the Chloromethylation of Linear Polystyrene and Polysulfone with Paraformaldehyde/Me3SiCl. Polym. Plast. Technol. Eng. 2001, 40, 275–281. [Google Scholar] [CrossRef]

| Sample | |||
|---|---|---|---|
| QPSF | 22.36 | 16.79 | 39.15 |
| PA | 0.47 | 37.49 | 37.96 |
| PN | 13.96 | 7.06 | 21.02 |
| P1AN | 1.50 | 43.39 | 44.89 |
| P2AN | 4.95 | 11.63 | 16.58 |
| P4AN | 0.96 | 36.10 | 37.06 |
| Code | Zero Order | First Order | Higuchi | Hixson–Crowell | Korsmeyer–Peppas | ||||||
|---|---|---|---|---|---|---|---|---|---|---|---|
| R2 | K0 | R2 | K1 | R2 | KH | R2 | k | R2 | k | n | |
| 1st stage | |||||||||||
| PN | 0.97 | 7.27 | 0.99 | −0.14 | 0.99 | 23.89 | 0.99 | −0.18 | 0.99 | 32.47 | 0.4 |
| P1AN | 0.97 | 8.62 | 0.99 | −0.16 | 0.99 | 28.35 | 0.99 | −0.21 | 0.99 | 29.33 | 0.5 |
| P2AN | 0.95 | 7.42 | 0.98 | −0.15 | 0.99 | 24.53 | 0.98 | −0.19 | 0.99 | 36.12 | 0.38 |
| P4AN | 0.90 | 6.58 | 0.94 | −0.16 | 0.95 | 22.04 | 0.93 | −0.19 | 0.97 | 45.84 | 0.3 |
| 2nd stage | |||||||||||
| PN | 0.66 | 0.47 | 0.99 | 0.009 | – | – | 0.69 | −0.006 | – | – | – |
| P1AN | 0.64 | 0.5 | 0.99 | 0.012 | – | – | 0.67 | −0.006 | – | – | – |
| P2AN | 0.65 | 0.49 | 0.91 | 0.02 | – | – | 0.67 | −0.004 | – | – | – |
| P4AN | 0.67 | 0.29 | 0.75 | 0.051 | – | – | 0.68 | −0.002 | – | – | – |
| Sample | Inhibition Zone (mm) | ||
|---|---|---|---|
| S. aureus | E. coli | C. albicans | |
| QPSF | 14.33 ± 0.46 | 22.56 ± 0.32 | - |
| PA | - | - | 17.63 ± 0.15 |
| PN | 32.63 ± 0.66 | 36.53 ± 0.55 | - |
| P1AN | 31.96 ± 0.30 | 37.90 ± 0.62 | 13.86 ± 0.05 |
| P2AN | 32.73 ± 1.00 | 39.67 ± 0.45 | 16.63 ± 0.51 |
| P4AN | 33.40 ± 0.26 | 39.40 ± 0.17 | 20.86 ± 0.83 |
Disclaimer/Publisher’s Note: The statements, opinions and data contained in all publications are solely those of the individual author(s) and contributor(s) and not of MDPI and/or the editor(s). MDPI and/or the editor(s) disclaim responsibility for any injury to people or property resulting from any ideas, methods, instructions or products referred to in the content. |
© 2025 by the authors. Licensee MDPI, Basel, Switzerland. This article is an open access article distributed under the terms and conditions of the Creative Commons Attribution (CC BY) license (https://creativecommons.org/licenses/by/4.0/).
Share and Cite
Dumbrava, O.; Rosca, I.; Ailincai, D.; Marin, L. Quaternized Polysulfones as Matrix for the Development of Broad-Spectrum Antimicrobial Coatings for Medical Devices. Polymers 2025, 17, 1869. https://doi.org/10.3390/polym17131869
Dumbrava O, Rosca I, Ailincai D, Marin L. Quaternized Polysulfones as Matrix for the Development of Broad-Spectrum Antimicrobial Coatings for Medical Devices. Polymers. 2025; 17(13):1869. https://doi.org/10.3390/polym17131869
Chicago/Turabian StyleDumbrava, Oana, Irina Rosca, Daniela Ailincai, and Luminita Marin. 2025. "Quaternized Polysulfones as Matrix for the Development of Broad-Spectrum Antimicrobial Coatings for Medical Devices" Polymers 17, no. 13: 1869. https://doi.org/10.3390/polym17131869
APA StyleDumbrava, O., Rosca, I., Ailincai, D., & Marin, L. (2025). Quaternized Polysulfones as Matrix for the Development of Broad-Spectrum Antimicrobial Coatings for Medical Devices. Polymers, 17(13), 1869. https://doi.org/10.3390/polym17131869

